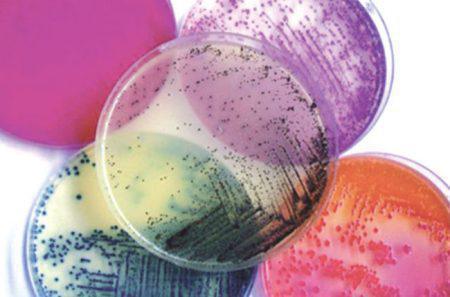
Antibiothérapie selon la pathologie Antibiothérapie selon la pathologie

Méningites
méningites communautaires
Signes de gravité d’une méningite bactérienne imposant l’hospitalisation en réanimation :
- un état de choc (Purpura fulminans),
- signes de localisation
- troubles graves de la conscience (Score de Glasgow < 8).
Pupura fulminans
- C3G (céfotaxime ou céftriaxone) i.v. immédiat
Méningite avec signes neurologiques de localisation :
- C3G
- + vancomycine
puis TDM cérébral et PL.
Importance de l’examen direct du LCR
Cg + (pneumo)
- C3G
- + vancomycine (40 à 60 mg/kg/jour) ;
Cg – (méningo)
- C3G ou amoxicilline ;
Bg + (listéria)
- amoxicilline (200mg/kg/jour)
- + gentamicine (3 à 5 mg/kg/jour) ;
Bg – (Haemophilus. Influenzae)
- C3G (céfotaxime 200 à 300mg/kg/jour).
Si examen direct négatif, l’antibiothérapie est fonction de la cellularité et et de la biochimie du LCR :
C liquide trouble (PNN), glycorachie basse
- C3G
- + vancomycine ;
LCR clair lymphocytaire, glycorachie basse
- amoxicilline
- + gentamicine
- + antibiothérapie antituberculeuse;
C LCR lymphocytaire, glycorachie normale
- aciclovir.
méningites nosocomiales et abcès cérébraux postopératoires
Le pneumocoque est en première ligne des méningites post-traumatiques.
- amoxicilline.
Méningites postopératoires
- L’examen bactériologique du LCR doit être systématique avant toute antibiothérapie ;
- Céfotaxime + Fosfomycine en première intention. Mais aussi en fonction de la bactérie suspectée : céftazidime, imipénème, fluoroquinolones ou vancomycine.
pneumopathies
pneumopathies communautaires
Association d’antibiotiques administrées par voie intraveineuse
- amoxicilline–acide clavulanique (2 g/8 heures) ou céfotaxime (2 g/8 heures) ou céftriaxone (2 g/jour) + érythromycine (1 g/8 heures) ou ofloxacine (200 × 2) ou lévofloxacine (500 × 2) ;
- En cas d’allergie prouvée à la famille des pénicillines et aux C3G : glycopeptide + ofloxacine ;
- Risque de P. aeruginosa (AtbTT fréquente, DDB, corticothérapie au long cours) : bêtalactamine antipseudomonas ciprofloxacine (400 mg/8 heures).
pneumopathies nosocomiales
Proposition d’antibiothérapie pour les pneumopathies nosocomiales acquises sous ventilation artificielle (PAV)
- PAV précoce < 7 jours, sans antibiothérapie préalable :
- céfotaxime ou céftriaxone ou amoxicilline–acide clavulanique
- PAV tardive > 7 jours, ou PAV précoce mais avec antibiothérapie préalable ou hospitalisation antérieure dans un service à risque :
- bêtalactamine anti-P. aeruginosa + amikacine ou ciprofloxacine; en association avec la vancomycine si facteurs de risque de SDMR.
- Prise en compte de legionella si facteurs de risque et/ou antigènes urinaires positifs ;
- Retour à l’antibiothérapie la plus simple efficace, dès que possible. Cette stratégie nécessite des : C des prélèvements fiables et réalisés avant tout traitement; la réalisation d’un antibiogramme quand la culture est positive.
infections urinaires
IU communautaires
- Fluoroquinolones ou C3G (céfotaxime ou ceftriaxone)
- Bithérapie dans les formes graves avec hypotension
- C3G + fluoroquinolones ou aminoside (nétilmicine ou gentamicine)
- Fluoroquinolones + aminoside en cas d’allergie aux bêtalactamines
- Pendant la grossesse : les fluoroquinolones sont contre-indiquées ; amoxicilline–acide clavulanique + aminoside (surtout si entérocoque)
IU nosocomiales
Discussion au cas par cas en fonction de :
- la colonisation du patient, de l’écologie du service et de l’examen direct de l’ECBU ;
- chez l’homme, des antibiotiques à forte diffusion prostatique doivent être proposés, en cas d’infection du tissu prostatique : fluoroquinolones ou cotrimoxazole.
infections intra-abdominales
communautaires et nosocomiales (péritonites, angiocholites, angiocholites post-CPRE, infection du liquide d’ascite, pancréatite)
Différents schémas d’antibiothérapie sont possibles en fonction du caractère communautaire ou nosocomiale de l’infection. Le traitement médical sera toujours associé au traitement chirurgical quand il est réalisable :
péritonites communautaires :
- amoxicilline–acide clavulanique (2 g × 3/jour) + aminoside (gentamicine ou nétilmicine 5 mg/kg) ;
- ticar–clavu (5 g × 3/jour) + aminoside ;
- céfotaxime ou ceftriaxone + aminoside ;
- entérocoque : rôle pathogène reconnu.
Pas de consensus pour le traitement des péritonites nosocomiales et postopératoires :
- pipéracilline–tazobactam (4,5 g × 4/jour) + amikacine (20 mg/kg × 1/jour) ;
- imipénème (1 g × 3/jour) + amikacine (20 mg/kg) ;
- ± vancomycine (15 mg/kg) si SAMR ou entérocoque résistant à l’amoxicilline ;
- ± fluconazole (800 mg/jour) ;
péritonites primaires du cirrhotique :
- amoxicilline–acide clavulanique (1,2 g/6 heures) ou céfotaxime (2 g/8 heures) ou céftriaxone (2 g/jour).
Pancréatites
La stratégie de prise en charge a été proposée par le conférence de consensus de 2001.
- Il n’y a pas d’indication à proposer une antibioprophylaxie (cf. consensus).
- L’antibiothérapie est débutée après ponctions sous TDM ou prélèvements peropératoire, réalisés devant la survenue d’un état septique.
- La faible diffusion des antibiotiques dans la nécrose pancréatique impose de tenir compte de données pharmacocinétiques, quand elles sont disponibles, pour guider le choix de l’antibiothérapie.
- En l’absence d’antibiothérapie préalable, le choix se porte sur l’imipénème ou les fluoroquinolones ou l’association céfotaxime et métronidazole.
- En cas d’antibiothérapie préalable, d’hospitalisation prolongée, de manoeuvres endoscopiques ou de nécrosectomie antérieure, le choix se porte sur l’association imipénème, vancomycine et fluconazole.
- L’antibiothérapie sera adaptée secondairement à l’antibiogramme des bactéries retrouvées dans les prélèvements peropératoires ou par ponction percutanée.
angiocholites aiguës
Angiocholite aiguë communautaire :
- amoxicilline–acide clavulanique + gentamicine ou nétilmicine;
- ticarcilline–acide clavulanique ;
- pipéracilline + métronidazole ;
- céfoxitime ;
- céfotaxime ou céftriaxone + métronidazole ;
- si signes de gravité association de gentamicine ou nétilmicine.
Angiocholite nosocomiale ou post CPRE :
- Cette situation représente un facteur de risque identifié d’infection à entérocoque :
- Pipéracilline–tazobactam + amikacine ;
- Imipénème + amikacine ;
- Ceftazidime + métronidazole + amikacine ;
infections cutanées et des tissus mous,
Classification des infections graves des parties molles.
- Les formes nécrosantes (dermohypodermites bactériennes nécrosantes ou DHBN et les fasciites nécrosantes ou FN) sont de véritables urgences médicochirurgicales. Dans 40 à 80 % des cas, toutes localisations confondues, c’est une flore mixte qui est retrouvée : anaérobies, entérobactéries, streptocoques, entérocoques et Staphylococcus aureus. Streptococcus pyogenes est retrouvé dans près de la moitié des prélèvements et dans 50 % des hémocultures prélevées chez des patients en choc septique. Le traitement antibiotique n’est qu’un adjuvant du traitement chirurgical qui repose sur des excisions larges.
- L’oxygénothérapie hyperbare n’a pas montré, de façon méthodologiquement satisfaisante, son efficacité.
Les DHBN – FN restent avant tout des urgences chirurgicales.
membres et région cervicofaciale :
- amoxicilline–acide clavulanique (2 g × 3/jour)
- + gentamicine ou nétilmicine (5 mg/kg/jour) ;
gangrène périnéale communautaire :
- C3G
- + métronidazole
- ou amoxicilline–acide clavulanique
- + gentamicine ou netilmicine ;
gangrène postopératoire :
- pipéracilline–tazobactam (16 g/jour) ou imipénème (1 g × 3/jour)
- + amikacine (20 mg/kg/jour)
endocardites
Valve native :
suspicion de staphylocoque communautaire :
- cloxacilline (2 g/4 heures)
- + gentamicine (1,5 mg/kg/12 heures) ou nétilmicine (3 mg/kg/12 heures) ;
sans élément d’orientation :
- amoxicilline–acide clavulanique (2 g/4 heures)
- + gentamicine (1,5 mg/kg/12 heures) ou nétilmicine (3 mg/kg/12 heures) ;
si allergie vrai aux pénicillines :
- vancomycine (15 mg/kg/12 heures)
- + gentamicine (1,5 mg/kg/12 heures) ou nétilmicine (3 mg/kg/12 heures).
Valve prothétique quelque soit l’ancienneté de la chirurgie:
cas général :
- vancomycine (15 mg/kg/12 heures)
- + rifampicine 600 mg/12 heures
- + gentamicine (1,5 mg/kg/12 heures) ou nétilmicine (3 mg/kg/12 heures);
si échec ou contexte particulier :
- vancomycine (15 mg/kg/12 heures)
- + ceftazidime 2 g/8 heures
- + gentamicine (1,5 mg/kg/12 heures) ou nétilmicine (3 mg/kg/12 heures)
infection sur cathéter
Il s’agit quasiment toujours d’une infection nosocomiale exposant à un risque élevée d’infection par une bactérie multirésistante. La stratégie thérapeutique doit comporter les étapes suivantes :
l’ablation du cathéter est l’étape la plus importante du traitement. Elle permet une culture quantitative du cathéter et la réalisation d’hémocultures après l’ablation de celui-ci ;
l’antibiothérapie probabiliste est débutée devant :
- un état septique grave et/ou une immunodépression ;
- la présence d’une prothèses vasculaires ou articulaires ou d’un pace-maker ;
- l’antibiothérapie doit être antistapyloccocique et anti BGN ;
- un sepsis sur cathéter périphérique impose la discussion d’une ligature-excision de la veine en cause notamment s’ils existent des signes locaux importants, une thrombophlébite ou sepsis sévère associé à des hémocultures toujours positives sous traitement adapté.
Les schémas suivants peuvent être proposés
- vancomycine (15 mg/kg × 2) + céfépime (2 g × 2) + gentamicine ;
- vancomycine (15 mg/kg × 2) + ceftazidime + amikacine ;
- vancomycine + imipénème + amikacine ;
- si facteurs de risque d’infection à levures : discussion de l’amphotéricine B ;
- adaptation à l’antibiogramme est impérative lors du retour de la culture du cathéter et des hémocultures.
sepsis sans porte d’entrée suspectée, antibiothérapie probabiliste
- infection communautaire : C3G (céfotaxime ou céftriaxone) + gentamicine ou nétilmicine + métronidazole ;
- infection nosocomiale (y compris les patients en institution ou hospitalisés dans les 30 jours précédents) :
- imipénème ou ceftazidime ou céfépime + amikacine + vancomycine ± métronidazole (inutile si imipénème).